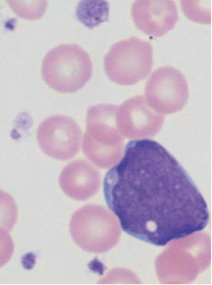
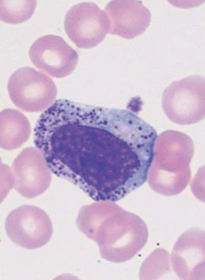
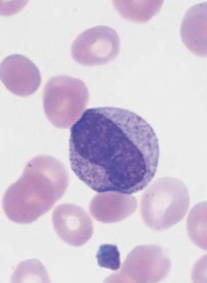
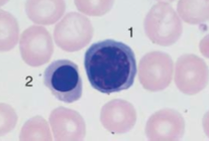
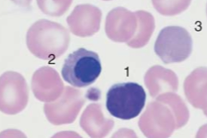
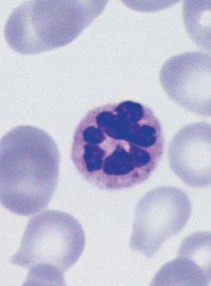
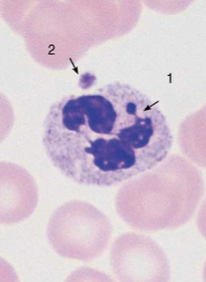
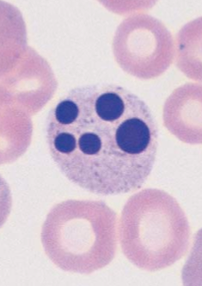
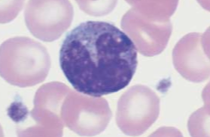
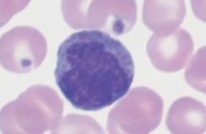

Number of cells on a peripheral blood manual differential count
200
Number of cells on a marrow aspirate manual differential count
500
Cells included in marrow aspirate differential
blasts, promonocytes, promyelocytes, myelocytes, metamyelocytes, bands, segmented neutrophils, eosinophils, basophils, monocytes, lymphocytes, plasma cells, erythroid precursors, mast cells (megas are not included)
Core biopsy should be…
1.5 cm in length, at a right angle to cortical bone, ≥10 partially preserved intertrabecular areas
Cells included in blast count
myeloblasts, monoblasts, megakaryoblasts
Myeloblast

Myelocyte

Metamyelocyte

PMNs with toxic granulation

PMN with peroxidase reaction

PMN with alkaline leukocyte phosphatase (ALP)
Hypersegmented (>/= 6) PMN
Drumstick as an appendage with thin filament bridge to the nucleus (associated with X-chromosome)

Very large PMN following chemotherapy
PMN after prolonged (>8 hours) storage
Monocyte
Monocyte